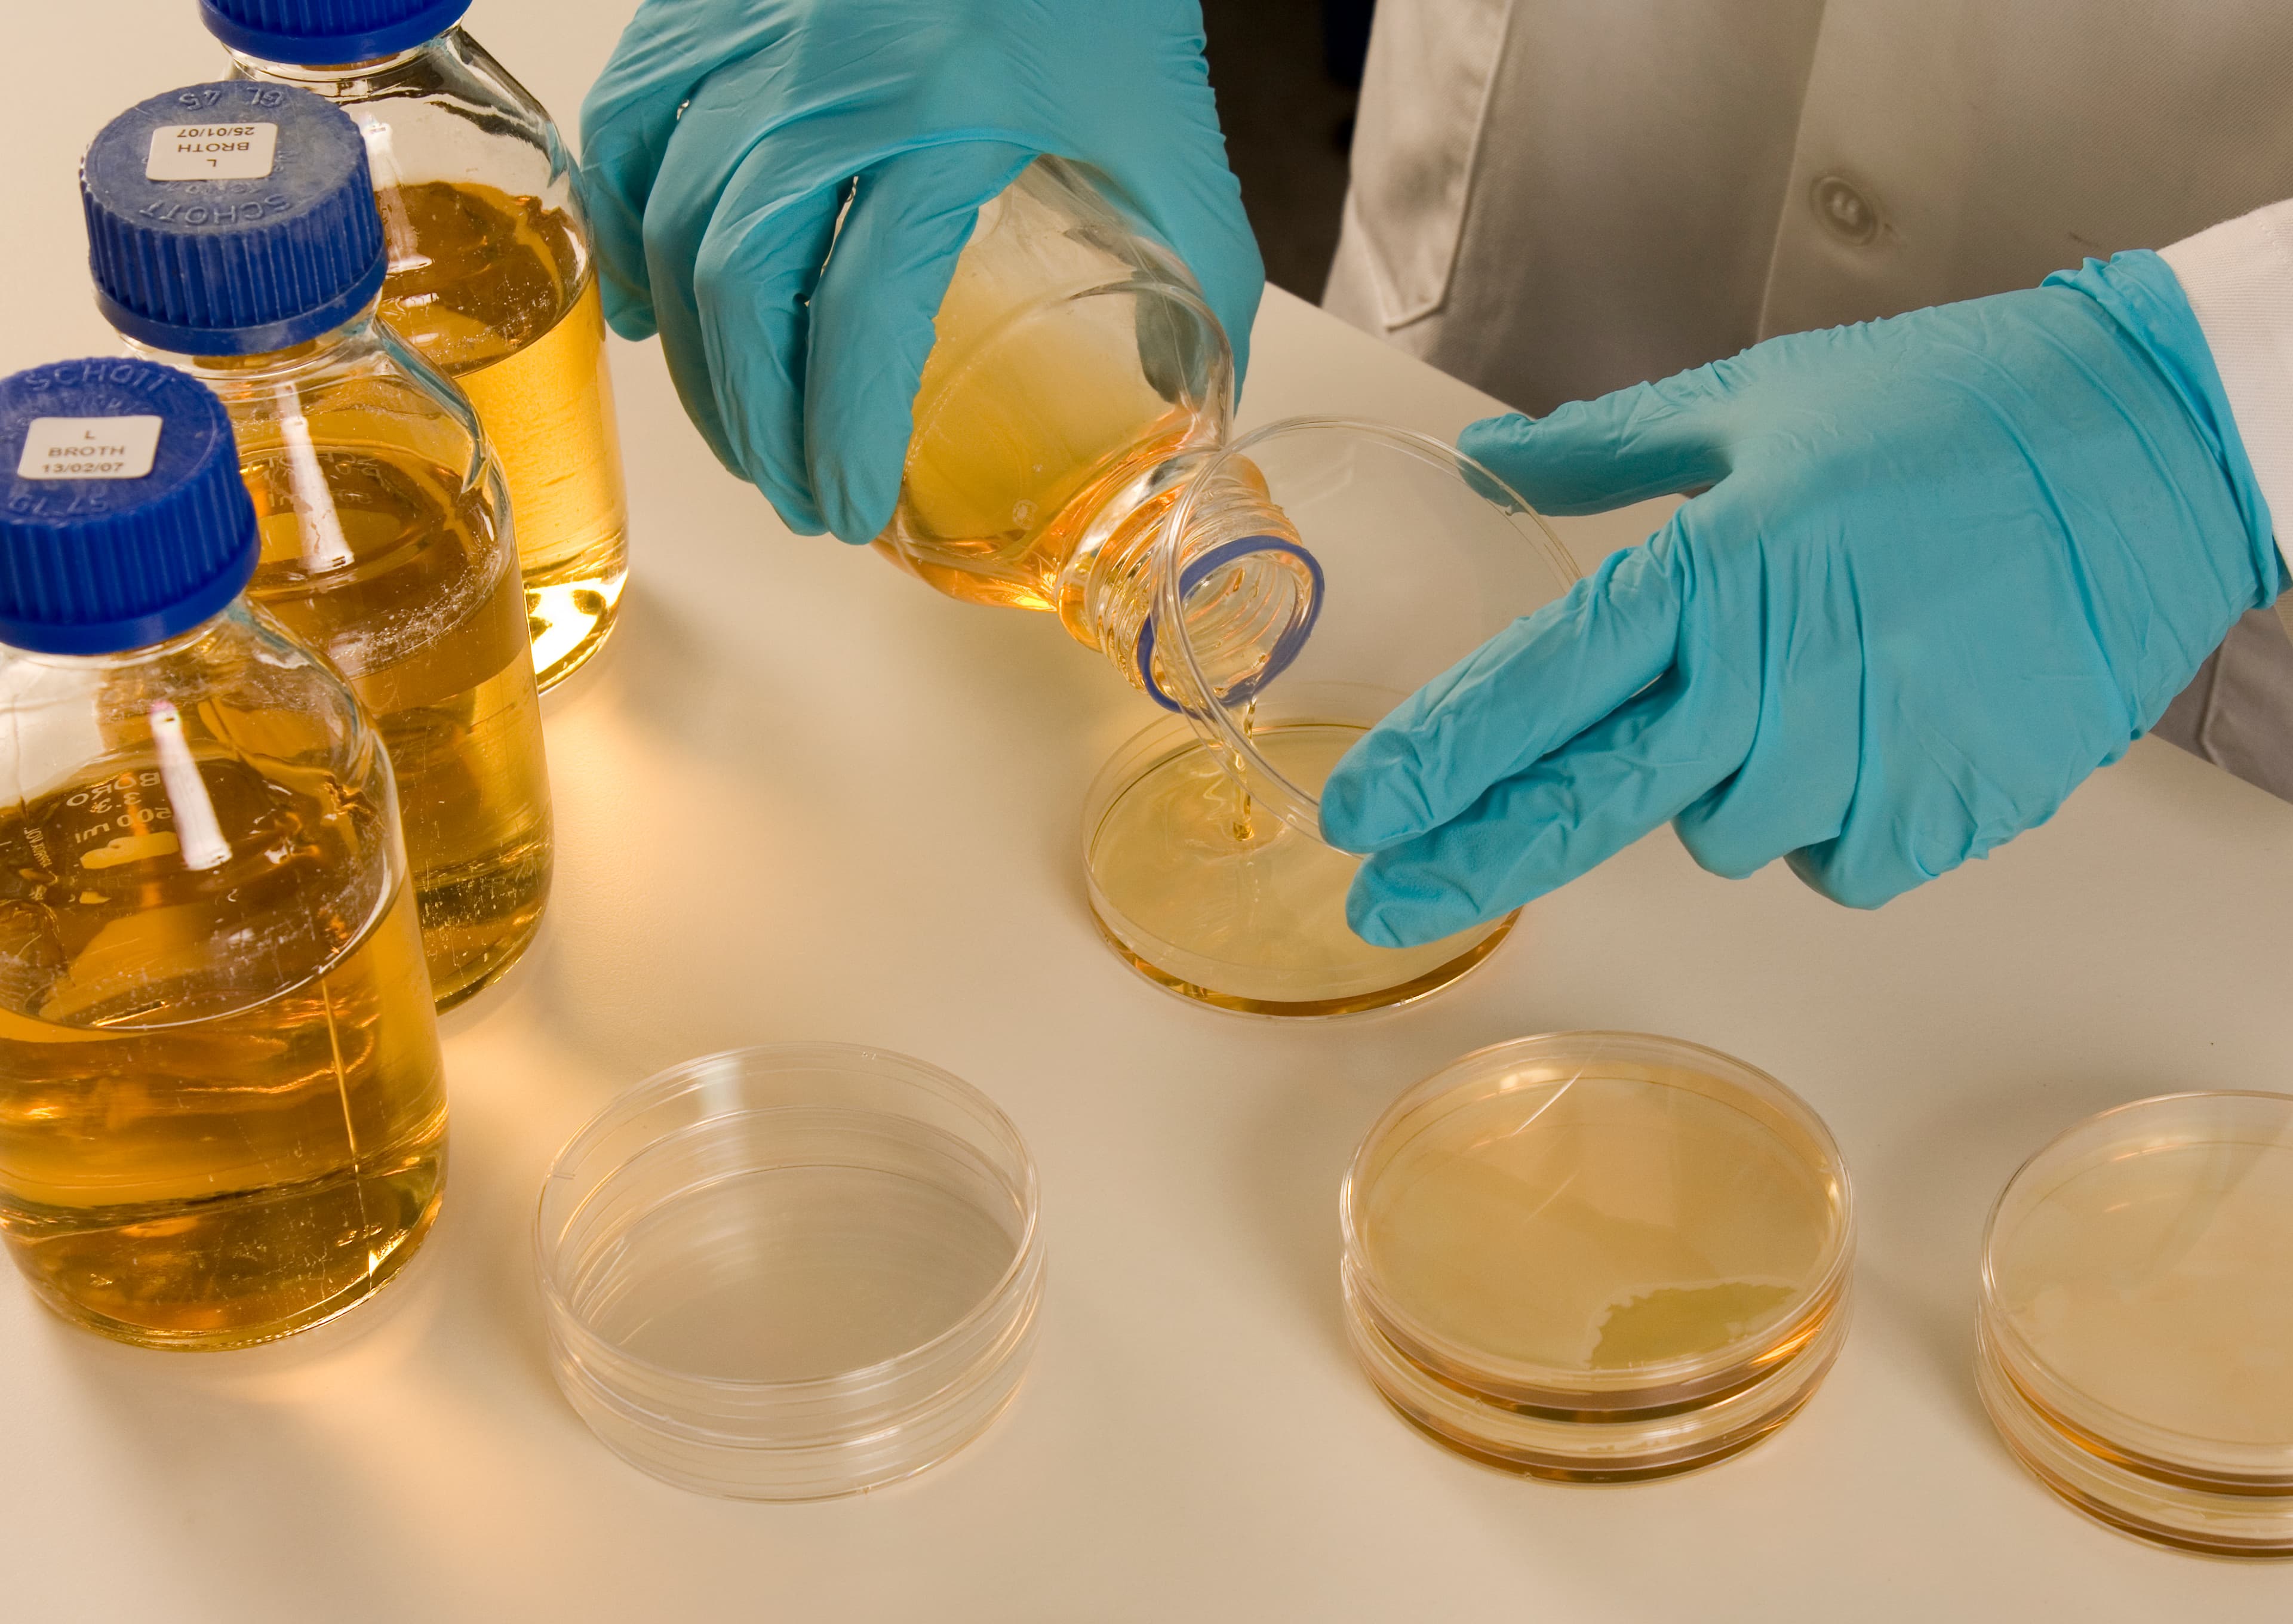
laboratory equipment- Culture plate samples.

Although survival for many types of cancer has improved, pancreatic cancer survival has lagged significantly behind in the last 40 years. The disease is particularly hard to treat, partly because it’s often diagnosed at a late stage. It’s one of our top priorities for research, because we want to give more hope to people with pancreatic cancer and their loved ones.

From studying the biology of pancreatic cancer cells in the lab to leading clinical trials testing cutting-edge treatments, our researchers are working hard to ensure more people survive pancreatic cancer.
Thanks to research, we've helped change the outlook for people with pancreatic cancer.

Meet people like Peter who have experienced first-hand how our research is making a difference. The life-saving research we do wouldn’t be possible without your support.
Over the last 40 years, cancer survival in the UK has doubled. In the 1970s just 1 in 4 people survived their disease for 10 years or more. Today 2 in 4 survive.
We want to accelerate progress and see 3 in 4 patients surviving the disease by 2034.
Browse the latest news, analysis and opinion from Cancer Research UK.
Want to find more information about our research or pancreatic cancer?